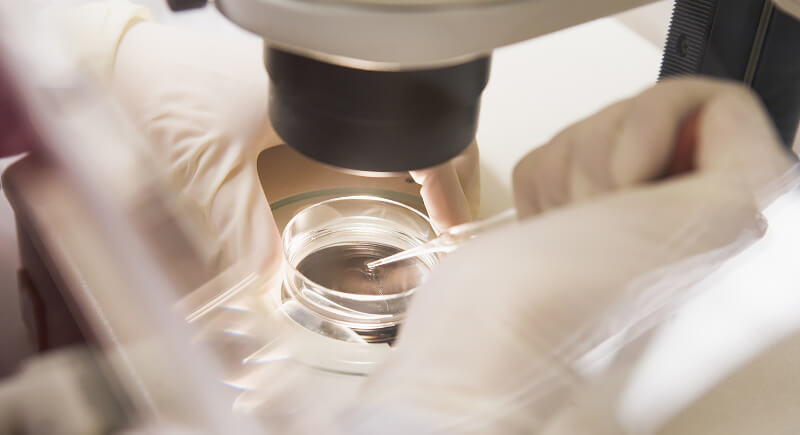

This Australian Man Became a Father at 93, and Science Is Baffled
Becoming a father at 93 was not something Dr. John Levin expected. Yet in early 2024, the Melbourne-based anti-aging specialist welcomed a baby boy with his wife, Dr. Yanying Lu, who is 37. The birth quickly drew global attention, not just because of Levin’s age, but because the couple’s path to parenthood involved years of loss, IVF treatment, and persistence. His late-life fatherhood has sparked curiosity, debate, and questions about what biology can still allow at the far edges of age.
A Language Class That Changed Everything

Credit: Instagram
After his wife of 57 years passed away, Levin decided to challenge himself with something new and signed up for Mandarin lessons. His teacher, Dr. Yanying Lu, was not impressed with his skills and told him to stop after three lessons. Still, they kept talking, and over time, casual conversations turned into dinner dates and eventually into marriage.
A Wedding in Las Vegas With No Baby Plans

Credit: Instagram
Levin and Lu married in Las Vegas in 2014, years before they ever discussed starting a family. At the time, they were focused on building a life together. That changed during the COVID-19 lockdowns when Lu began reflecting on life’s direction and realized she wanted a lasting piece of Levin.
IVF Success Without Delay
Credit: Canva
When they decided to try for a baby, they turned to IVF using donor sperm. The process, known for being unpredictable, worked for them on the very first attempt. Lu became pregnant quickly, and Levin described the moment he held his newborn son as “unbelievable.”
A Newborn’s Arrival Coincided With a Farewell

Credit: Instagram
In February 2024, their son Gabby was born. Just five months later, Levin’s eldest son, Greg, died at 65 from motor neurone disease. The emotional weight of welcoming a child while grieving another was not lost on Levin. He acknowledged the timing with grace, recognizing the strange overlap of joy and sorrow.
Most People Think He’s the Great-Grandfather

Credit: Instagram
Strangers often assume Levin is Gabby’s great-grandfather. He takes it in stride and understands why people do the math that way. When they learn the truth, the reaction is usually disbelief. Lu has grown used to the confusion, and the couple does not feel the need to correct every assumption.
He Doesn’t Do Diapers, and That’s Fine

Credit: heraldsun
Lu has been open about the parenting dynamic in their household and describes her husband as “very old-fashioned.” Levin never changed diapers, nor did he ever plan to, but that hasn’t caused friction. She handles the faster-paced tasks of baby care, while Levin brings steadiness and patience.
He Lives by the Habits He Teaches

Credit: halfpoint
As an anti-aging doctor, Levin has always practiced what he preached. He avoids vices, walks to work, exercises twice a week, and doesn’t eat before noon. He has even undergone stem cell therapy. While he credits much of his longevity to daily discipline, he’s realistic about the role genetics may have played.
He Wants to See His Son Turn 21

Credit: Instagram
Levin doesn’t just hope to stay healthy—he has a specific goal in mind. He wants to live to 113 so he can attend his son’s 21st birthday. He knows the odds are against him, but setting that milestone gives him purpose. It shapes how he approaches his routines and mindset.
His Family Already Included Generations Before Gabby

Credit: Facebook
Before Gabby was born, Levin had already experienced parenthood, grandparenthood, and great-grandparenthood. Sources confirm he has adult children, ten grandchildren, and at least one great-grandchild, making this new chapter of fatherhood unlike anything he has experienced before.
Their Story Has Drawn Public Attention

Credit: Instagram
Levin and Lu have gone public with their story, attracting widespread media interest for their age gap and late-life parenthood. While they acknowledge public reactions, they emphasize that their decisions are guided by what makes them happy as a family.